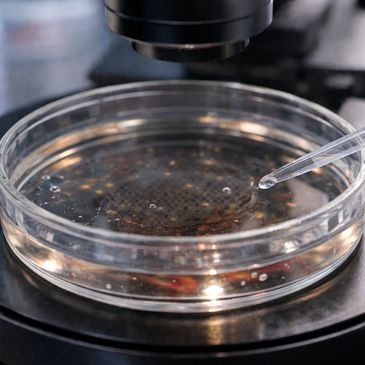

About STEM Brain Cell Lab Laboratory
Projects
Faculty of Medicine
Projects
At STEM Brain Cell Lab Laboratory, we are dedicated to conducting groundbreaking research in the field of {scientific field}. Our mission is to advance the knowledge and understanding of {scientific field} through rigorous scientific inquiry.
.jpg/:/cr=t:0%25,l:13.09%25,w:73.83%25,h:100%25/rs=w:365,h:365,cg:true)
Our Team
Faculty of Medicine
Projects
Our team of expert scientists and researchers bring a wealth of knowledge and experience to STEM Brain Cell Lab Laboratory. With backgrounds in {related fields}, our team is committed to pursuing innovative solutions to the most pressing challenges in {scientific field}.
.jpg/:/cr=t:0%25,l:12.51%25,w:74.98%25,h:100%25/rs=w:365,h:365,cg:true)
Faculty of Medicine
Faculty of Medicine
Faculty of Medicine
Our state-of-the-art research facilities are equipped with the latest technologies and instrumentation to support cutting-edge research in {scientific field}. From our high-throughput screening facilities to our advanced imaging and microscopy labs, we have the tools necessary to make groundbreaking discoveries.
This website uses cookies.
We use cookies to analyze website traffic and optimize your website experience. By accepting our use of cookies, your data will be aggregated with all other user data.